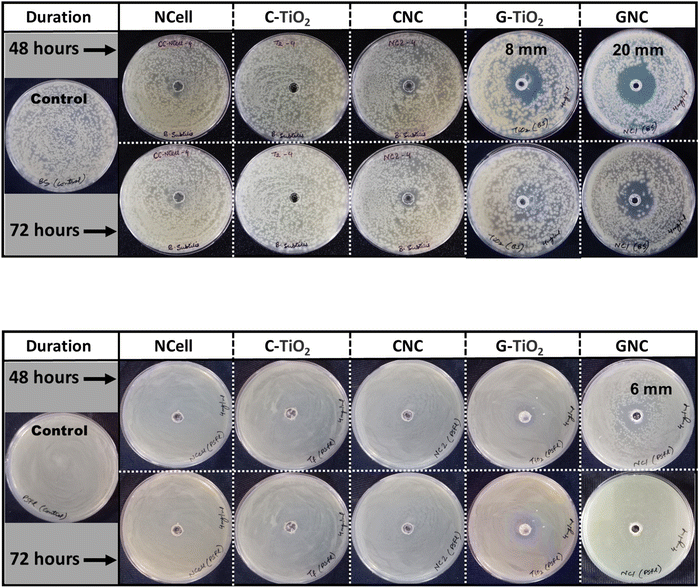
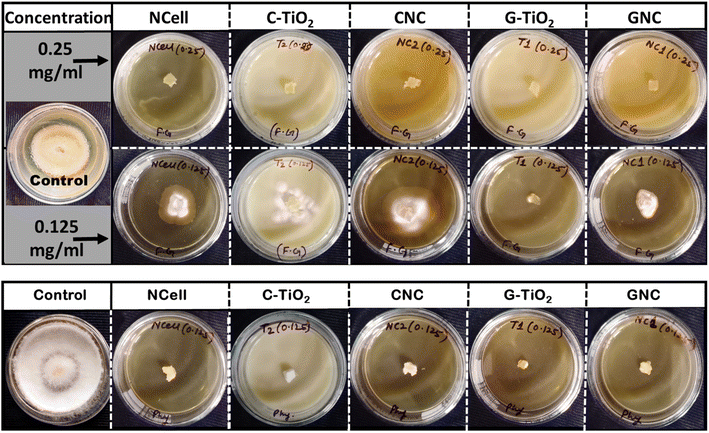

Synergistic antimicrobial effects of waste cotton cloth extracted cellulose with phytofabricated TiO2 for potential application in agriculture
Received
16th June 2024
, Accepted 30th November 2024
First published on 7th December 2024
Abstract
A substantial economic loss in agriculture due to plant microbial diseases has driven attention towards developing nanomaterials as antimicrobial agents for crop protection. The currently available fungicides and pesticides are highly toxic and non-degradable, causing environmental pollution and even being harmful to consumers of agricultural products. However, this work attempts to develop a non-toxic and biocompatible nanomaterial as a good antimicrobial agent. In this regard, a waste product, i.e., waste or used cotton cloth, has been recycled and used as a source of cellulose (natural biopolymer) extraction and for isolation of nanocrystalline cellulose (NCell) as well. Another biocompatible nanomaterial, titanium oxide (TiO2), was synthesized using Azadirachta indica leaf extract to utilize the advantage of phytochemicals in the green extract. Furthermore, the two eco-friendly nanocomposites of NCell were prepared as nanomedicines, one with commercially available chemical TiO2 (CNC) and another with green TiO2 (GNC). The nanocomposites (CNC and GNC), in comparison with their individual nanomaterials (NCell and TiO2), were examined against phytopathogens: Xanthomonas campestris pv. campestris (Xcc), Bacillus subtilis (BS) and Pseudomonas fluorescens (Psfl); fungi: Fusarium graminearum and Phytophthora spp. The results illustrated the synergistic effects of NCell and TiO2 as nanocomposites showing a stronger and longer ability to inhibit pathogen growth and, thus, proved GNC to be an excellent antimicrobial agent for crop protection in agriculture.
Sustainability spotlight
The study on developing nanomaterials as antimicrobial agents for crop protection aligns well with the scope of sustainable food technology. This research focuses on sustainable agricultural practices by recycling waste cotton cloth to extract nanocrystalline cellulose (NCell) and synthesizing biocompatible titanium oxide (TiO2) nanoparticles using Azadirachta indica leaf extract. These eco-friendly nanocomposites (CNC and GNC) demonstrated significant antimicrobial efficacy against various phytopathogens and fungi, highlighting their potential to replace toxic, non-degradable pesticides and fungicides. This innovative approach not only addresses environmental and health challenges associated with conventional agrochemicals but also contributes to the circular economy and sustainable intensification of food production.
|
1. Introduction
Agriculture suffers from significant losses globally due to microbial plant diseases caused by bacteria, fungi, and viruses. These pathogens threaten food security by reducing crop yield and quality.1 Despite plants' natural defense mechanisms, harmful pathogens such as Pseudomonas syringae2 and fungi such as Fusarium spp. and Alternaria spp. continue to cause extensive damage. These fungi often produce toxic mycotoxins, endangering consumers and animals.3 The widespread use of synthetic fungicides and antimicrobials in agriculture has serious drawbacks, including toxicity, non-biodegradability, environmental pollution, and potential carcinogenic effects, necessitating the development of safer alternatives.
Nanotechnology offers innovative solutions for managing plant diseases sustainably. Metal oxide nanoparticles,4–8 including TiO2, MgO, and ZnO, as well as graphene oxide,9 silver and gold nanoparticles,10,11 have demonstrated potent antimicrobial activity. For example, MgO nanoparticles combat soilborne pathogens,12 while TiO2 nanoparticles inhibit microbial cells by generating reactive oxygen species (ROS). Silver nanoparticles (AgNPs) are examined as measures against the bacterium Xanthomonas campestris pv. campestris (Xcc).13 However, the high cost and potential environmental risks associated with silver and gold nanoparticles limit their application in agriculture. The present study addresses these challenges by developing cost-effective, eco-friendly nanocomposites using waste-derived cellulose and green-synthesized TiO2 nanoparticles. Cellulose, a naturally abundant, biodegradable polymer, was extracted from waste cotton cloth and processed into nanocrystalline cellulose (NCC). NCC offers numerous benefits,14,15 such as a high surface area, excellent heat resistance, and functional groups (hydroxyl and carbonyl) that enhance antimicrobial properties. It has applications in various industries,16–18 including pharmaceuticals, food packaging, and textiles, and also has great prospects for biomedical applications such as drug delivery, antibacterial wound dressing, antimicrobial films, and photobacterial nanofillers for food packaging.19–22 The presence of a large number of chemical groups (hydroxyl or carbonyl) on its surface exhibits a high affinity towards various contaminants.23 This property helps cellulose-based nanomaterials used for the adsorption of charged contaminants which attack the pathogen's surface to weaken or damage its cell wall. Incorporating another biocompatible nanomaterial24 further amplifies these properties, creating nanocomposites with enhanced structural and functional capabilities to strengthen antimicrobial potency.
TiO2 was chosen as another nanomaterial for its stability, biocompatibility, and antimicrobial potency.25–27 Notably, its photocatalytic properties produce ROS that damage bacterial and fungal cells,28–30 making it a promising material for plant disease control.31–33 The study employed a green synthesis method to produce TiO2 nanoparticles using Azadirachta indica (neem) leaf extract,34 known for its rich phytochemical composition. Neem has been valued for centuries for its antimicrobial, anti-inflammatory, and antioxidant properties, with over 300 bioactive compounds that enhance plant defense mechanisms. The nanocomposites were prepared by combining NCC with both green-synthesized and commercially available TiO2 nanoparticles. The materials were characterized using advanced analytical techniques, including transmission electron microscopy (TEM), X-ray diffraction (XRD), and UV-Vis spectroscopy, to assess their structural and optical properties. These nanocomposites were then evaluated for their antimicrobial efficacy against key phytopathogens and beneficial microbes.
The primary bacterial pathogen tested was Xanthomonas campestris pv. campestris (Xcc), responsible for black rot in Brassicaceae crops35–37 such as cabbage, cauliflower, and broccoli. This disease causes V-shaped lesions on leaves, leading to significant yield losses. As per the reported literature,13,38–40 only silver, copper and chitosan nanoparticles have been demonstrated against Xcc. These NPs are either expensive or not eco-friendly. However, the nanomaterials explored in the present work are earth-abundant, cost-effective, non-toxic, and biocompatible. This work is a first attempt to prepare such nanomaterials with efficient antimicrobial strength against chosen antimicrobials, especially Xanthomonas campestris pv. campestris (Xcc). However, cellulose and TiO2 have been explored for their antimicrobial action against different microbes but not against Xcc and other microbes explored in the present work. Moreover, only a few studies have reported antimicrobial properties of nanocomposites of cellulose and TiO2; one such report41 has demonstrated bacterial cellulose with CQD-TiO2 nanocomposite action against S. aureus and E. coli bacteria only. The present work provides first-hand information on the reporting of microbicidal action of cellulose-TiO2 nanocomposites against Xanthomonas campestris pv. campestris (Xcc) and other fungicides. Antifungal activity was assessed against Fusarium graminearum and Phytophthora spp., pathogens causing severe diseases such as Fusarium head blight in cereals (wheat and barley)42,43 and water- and soil-borne diseases in citrus,44,45 respectively. Both fungi are highly destructive, with F. graminearum producing mycotoxins such as deoxynivalenol, which poses risks to human and animal health. Additionally, the compatibility of the nanocomposites with beneficial biocontrol agents, Bacillus subtilis and Pseudomonas fluorescens, was also studied. These microbes play vital roles in suppressing plant diseases and enhancing soil health. B. subtilis manages bacterial wilt in tomatoes caused by Ralstonia solanacearum,46,47 while P. fluorescens protects seeds and roots from fungal infections.48 The obtained antibacterial and antifungal results of nanocomposites were analyzed and compared with those of each other and their individual parent components. Thus, the present work aims to utilize the synergistic effect of TiO2 and cellulose to increase their strength to damage bacterial cell growth without affecting the growth of biocontrol agents. Hence, the potential of prepared nanocomposites has been demonstrated for plant disease management or crop protection in agriculture.
2. Materials and methods
2.1 Materials used
Waste cotton cloth was picked from old daily used clothes. The 10% NaOH solution and 50% hydrogen peroxide used for the extraction process were purchased from Sigma-Aldrich. Acid treatment of extracted cellulose was done using concentrated sulphuric acid (98 wt%). The solvents used for washing and other testing purposes are DI water and absolute ethanol (99.9%). All the reactants and solvents used in the experiment were of analytical grade. The Azadirachta indica leaves were obtained from the ICAR-Indian Agricultural Research Institute campus. Titanium tetra isopropoxide (TTIP) with 99.99% purity was used as a precursor for the synthesis of green TiO2, while commercially available titanium(IV) oxide (TiO2) with 99.7% purity was used as chemical TiO2 (C-TiO2). TTIP and chemical TiO2 were obtained from Merck Chemicals Limited. The bacterial strain Xanthomonas campestris pv. campestris (Xcc) Xcc-C7, Bacillus subtilis DTBS-5 (BS), and Pseudomonas fluorescens DTPF-3 (PSFL) were obtained from the bacteriology lab, Division of Plant Pathology, ICAR-Indian Agricultural Research Institute. The fungal pathogens F. graminearum and Phytophthora spp. were obtained from the ITCC department of ICAR-Indian Agricultural Research Institute.
2.2 Synthesis
2.2.1 Cellulose extraction from cotton cloth.
According to the extraction process,49 waste cotton cloth, preferably white cotton cloth (free from dyes), was washed with detergent and rinsed properly to get it dried naturally in the sunlight. It was later cut into small pieces and dispersed in 10% NaOH solution at 70 °C temperature for 2 h. It was then washed with DI water and further treated with hydrogen peroxide (50%) at a temperature of 70–80 °C for 3 h. When the dispersion becomes off-white, then the pH was maintained using NaOH and acetic acid at 7. It was then washed with DI water repeatedly until it became a clean white solid which was further immersed in DI water with constant stirring overnight. This resulted in a stable colloid marked as Cotton cloth extracted Cellulose (CCell).
2.2.2 Isolation of nanocrystalline cellulose.
0.62 mol CCell was treated with 10 ml H2SO4, added dropwise at a temperature of 50 °C for about an hour. The reaction was terminated by adding an equal amount of cold water to the heated solution. The solution was then washed with DI water thrice using centrifugation at 7000 rpm. The sediment was dried at 60 °C for an hour, and the obtained nanocrystalline cellulose powder was marked as NCell.
2.2.3 Preparation of Azadirachta indica leaf extract.
10 g of freshly finely chopped Azadirachta indica leaves were completely clean with deionized water and heated for 45 min with 50 ml of deionized water during constant stirring. The aqueous extract was filtered with Whatman filter paper no. 1 to eliminate any remaining impurities and kept at 4 °C for further use.
2.2.4 Green synthesis of TiO2 nanoparticles.
The titanium dioxide nanoparticles were synthesized using Azadirachta indica leaf extract and titanium tetra isopropoxide as a precursor. According to the procedure, 4 ml of titanium tetra isopropoxide precursor was added to 50 ml of green extract, and the solution was heated in a conical flask at 80 °C for 3 h with constant stirring. The phytochemicals found in leaf extract contribute to the conversion of metal salts to metal oxide nanoparticles and are also in charge of the reaction mixture's color change of particles. The color change from green to yellowish green confirmed the formation of nanoparticles. The reaction mixture was centrifuged at 5000 rpm for 15 minutes to separate the synthesized TiO2 nanoparticles. The obtained sediment was dried in the oven overnight at 60 °C and further calcined at 400 °C for about 3 h in a furnace. The dried white powder obtained was the anatase form of TiO2 nanoparticles which was stored in a glass bottle and marked as G-TiO2. The anatase form of TiO2 is known to be the most stable and highly non-toxic in nature with relatively low cost.
2.2.5 Preparation of nanocomposites.
0.2 g NCell was dispersed in 40 ml ethanol/DI water solution with a ratio of 1
:
1 and magnetically stirred. After about 15 min, 0.2 g of TiO2 NPs (G-TiO2 or C-TiO2) were added to the suspension, and the stirring was continued for another 10 min. The obtained white solution was further ultrasonicated for 3 h followed by heating for half an hour at 70 °C. Later, heating was stopped, but the solution was kept on stirring overnight for homogeneous dispersion of nanoparticles. Next, the solution was centrifuged at 5000 rpm twice with ethanol and finally with DI water. The obtained sediment was dried at 50 °C for an hour to get the powdered nanocomposites marked as GNC (for G-TiO2) and CNC (for C-TiO2).
2.3 Characterization techniques
The synthesized nanoparticles' shape and size were analyzed using a transmission electron microscope (JEM 1011 model TEM). The well-sonicated ethanol dispersion of all the prepared nanomaterials was used to prepare carbon-coated copper TEM grids for testing. The absorption profile of all the samples was analyzed by UV-visible spectroscopy (Analytik Jena SPECORD 210 PLUS double beam UV-visible spectrophotometer). The diffraction pattern showing the phase composition of the nanocomposites in comparison with their parent components was analyzed by using a powder X-ray diffractometer (XRD) using CuKα radiation of wavelength (λ = 1.5418 Å) in the range of 2θ = 20° to 80° with a scan rate of 0.02 deg per second. Each measurement of XRD was recorded using ∼50 mg of well dried powdered sample. The data obtained from XRD and UV-visible spectroscopy were plotted using Origin software.
2.4
In vitro analysis of the antimicrobial properties
2.4.1 Bacterial culture.
All the bacterial strains (Xcc, BS and Psfl) were cultured in nutrient broth (NB) (SRL, India) for 24–48 h at 28 °C with 200 rpm in a rotary shaker. The optical density of bacterial culture was measured using a spectrophotometer (Thermo Fisher Scientific, USA) at a 600 nm wavelength and maintained at a 0.5 McFarland unit – 1.5 × 108 cfu ml−1.
2.4.2 Antibacterial activity.
The antibacterial activity of nanomaterials (NPs and nanocomposite NC) was evaluated using the agar well diffusion method18,50,51 against X. campestris pv. campestris, B. subtilis and Pseudomonas fluorescens. Nutrient Agar (NA) plates were prepared by spreading 100 μl of 1.5 × 108 cfu ml−1 bacterial suspension evenly over solidified nutrient agar. Then, a well of 5 mm was punctured in these bacterial NA plates, and 50 μl of nanomaterial to be tested was poured into the well. The prepared plates were kept at 28 °C for 48 to 72 h in an incubator. The inhibition zone (IZ) was observed at 48 and 72 h of incubation. The experiment was conducted at different concentrations (2, 4 and 8 mg ml−1) of nanomaterials, and the results mentioned here present the optimized concentration. Each concentration has been tested thrice, and the results were repeatedly the same with an uncertainty of ±1 mm IZ.
2.4.3 Antifungal activity.
The poison food agar assay has been used to evaluate the nanomaterials' antifungal activity against mycopathogens – F. graminearum and Phytophthora spp. Potato dextrose agar (PDA) medium plates were prepared and supplemented with different concentrations (4, 2, 1, 0.5, 0.25 and 0.125 mg ml−1) of the samples. A small plug of 3-day mycelial growth of F. graminearum and Phytophthora spp. was placed on the prepared PDA plates and incubated at 28 °C for 5 days. The results were observed after 5 days of incubation.
3. Results and discussion
3.1 X-ray diffraction pattern analysis
The diffraction peaks recorded using XRD spectra (shown in Fig. 1) represent the crystalline phases of the prepared nanocomposites (CNC and GNC) as compared with their individual components (NCell and TiO2), reflecting their joint contributions in composites. The characteristic peaks of TiO2 (both chemical and green synthesized) are indexed according to the JCPDS card no. 21-1272, which reflects the pure anatase phase.52 On the other hand, the XRD spectra of nanocrystalline cellulose featured three characteristic peaks with 2θ = 16.4°, 22.5°, 34.5° corresponding to (110), (200) and (004) planes, respectively.53–55 However, the characteristic peak of NCell corresponds to the (200) plane, and XRD peaks of TiO2 correspond to (101), (004), (200), (105), (211), and (204) planes simultaneously featured in XRD spectra of nanocomposites (CNC and GNC). This confirms the successful formation of nanocomposites featuring the contribution of both NCell and TiO2.
 |
| | Fig. 1 X-ray diffraction pattern of nanocrystalline cellulose (NCell), C-TiO2 (chemical TiO2), G-TiO2 (green synthesized TiO2), CNC (NCell : C-TiO2 nanocomposite) and GNC (NCell : G-TiO2 nanocomposite). | |
The X-ray diffraction pattern has also been used to determine the crystallite size in a solid by using the Debye Scherrer equation.56,57
D = Kλ/β cos θ |
where
D = crystalline size of the nanoparticle.
K = Scherrer constant equals 0.98.
λ = Wavelength of X-rays (1.54 Å).
β = Full width at half maxima.
The calculated value of crystallite size of nanomaterials has been recorded and is shown in Table 1.
Table 1 The crystallite size of all the samples calculated by using the Debye Scherrer equation
| Sample |
β
|
2θ |
D (nm) |
| NCell |
0.3 |
22.42 |
28.18 |
| C-TiO2 |
0.38 |
25.23 |
21.25 |
| G-TiO2 |
0.4 |
25.28 |
22.37 |
| CNC |
0.52 |
25.32 |
16.35 |
| GNC |
0.72 |
25.44 |
11.81 |
3.2 Optical characteristics
The absorption spectra shown in Fig. 2 have been obtained using UV-visible spectroscopy for optical analysis. It can be clearly seen that cellulose and TiO2 both exhibit absorption in the ultraviolet region. Considering that the slope of the absorption band corresponds to the absorption edge of a material, the NCell absorption is slightly blue-shifted compared to that of CCell. Similarly, the C-TiO2 absorption peak is blue-shifted compared to that of G-TiO2. This blue shift in the absorption profile suggests particle size reduction. However, the absorption spectra of the nanocomposite showed the characteristic features of both NCell and TiO2. This suggests the contribution of both individual parent components to the optical properties of nanocomposites, similar to the inference obtained from XRD spectra.
 |
| | Fig. 2 Absorption profile of cotton extracted cellulose (CCell), nanocrystalline cellulose (NCell), C-TiO2 (chemical TiO2), G-TiO2 (green synthesized TiO2), CNC (NCell : C-TiO2 nanocomposite) and GNC (NCell : G-TiO2 nanocomposite) obtained from UV-visible spectroscopy. | |
3.3 Structural and morphological analysis
The particle shape and size of prepared materials were analysed using TEM images shown in Fig. 3. Image (a) depicts the cluster of long fibers of cellulose extracted from waste cotton cloth while nanocrystalline cellulose (NCell shown in image b) isolated from extracted microcrystalline cellulose shows spherical nanoparticles of size ∼35–50 nm. Images (c) and (d) exhibit commercial TiO2 of particle size ∼20 nm and green synthesized TiO2 with particle size ∼20–25 nm, respectively. Thus, the particle size of C-TiO2 is found to be lower as compared to G-TiO2, commensurating well with the UV-visible absorption results. However, images (e) and (f) belong to the nanocomposites of NCell with commercial chemical TiO2 (CNC) and green synthesized TiO2 (GNC), respectively. The TEM image of CNC depicts spherical nanoparticles of size ∼16–20 nm, while that of GNC depicts ∼7–12 nm spherical nanoparticles. Moreover, particle agglomeration is noted in the CNC image, while the GNC image depicts evenly distributed nanoparticles. Hence, the TEM results suggest that the nanocrystalline cellulose nanocomposite with green synthesized TiO2 exhibits better morphology than the nanocomposite of chemical TiO2, as GNC shows good particle distribution with lower or no agglomeration. This indicates that the phytochemical-rich green extract in the TiO2 material played an important role in the preparation of nanocomposites. Moreover, the results obtained from TEM commensurate well with the crystallite size calculated using X-ray diffraction patterns.
 |
| | Fig. 3 Images recorded using a transmission electron microscope (TEM) for (a) cotton-extracted cellulose, (b) nanocrystalline cellulose, (c) chemical TiO2, (d) green synthesized TiO2, (e) CNC (NCell : C-TiO2 nanocomposite) and (f) GNC (NCell : G-TiO2 nanocomposite). | |
Furthermore, the particle size distribution has been analyzed by using dynamic light scattering. Although DLS is too sensitive toward the presence of even small aggregates as I (scattering intensity) αR6 (particle radius), it is used to determine the size distribution profile of particles in a suspension, measuring the hydrodynamic size of particles. Thus, it provides the nanoparticle size much larger than that analyzed using TEM results. Therefore, DLS data owe to hydrodynamic diameters based on ligands, ionic species, capping agents, solvents, etc. However, it can be appropriately utilized to monitor the PDI (polydispersity index) value to determine its monodispersity/polydispersity nature. The PDI value represents the particle size distribution, which should ideally be less than 1 to show monodispersity. Table 2 presents the particle hydrodynamic size of all the samples along with their PDI values. It has been found that the PDI value of all the samples is less than 1 owing to their monodispersive nature. Fig. 4 describes the particle size distribution of all the synthesized nanomaterials, while the inset figure shows the plot of the DLS correlation coefficient versus time. The particle size distribution profile shows a broad peak of chemical TiO2 while the sharpest peak of the phytofabricated nanocomposite i.e., GNC. Similarly, the correlation decay of GNC is steeper than that of all other samples, and its PDI value (0.2) is also lower comparatively, which indicates that it is more stable or monodispersive than other nanomaterials. Thus, the DLS analysis also makes evident that the phytofabricated nanocomposite is the most stable and monodispersive nanomaterial.
Table 2 The hydrodynamic size of particles of all the samples, along with their PDI value obtained by DLS analysis
| Sample |
Hydrodynamic size (nm) |
PDI value |
| NCell |
78.8 |
0.584 |
| C-TiO2 |
58.8 |
0.9 |
| G-TiO2 |
58.8 |
0.4 |
| CNC |
37.8 |
0.327 |
| GNC |
21 |
0.2 |
 |
| | Fig. 4 DLS spectra showing the particle size distribution of (a) nanocrystalline cellulose (NCell), (b) chemical TiO2 (C-TiO2), (c) green synthesized TiO2 (C-TiO2), (d) CNC (NCell : C-TiO2 nanocomposite) and (e) GNC (NCell : G-TiO2 nanocomposite); inset showing the correlation coefficient versus time plot of all the samples. | |
3.4 Antibacterial study of synthesized nanomaterials
The antibacterial properties of nanocomposites (CNC and GNC) in comparison with their parent components (NCell, chemical TiO2 and green TiO2) were analyzed by the agar well diffusion method at different concentrations (2, 4 and 8 mg ml−1). Initially, the experiment was conducted at an 8 mg ml−1 concentration, but all the nanomaterials showed no activity at this concentration. It might be the case that the density of nanoparticles is too high, providing higher chances for agglomeration, due to which the nanoparticles could no longer maintain smaller particle size. Since particle size is one of the major factors responsible for the defensive mechanism against pathogens, small particles comparatively have a high ability to rupture and penetrate the bacterial cell wall.58–60 Keeping this in mind, the concentration of the nanomaterials has been reduced to 4 mg ml−1 and tested against phytopathogen X. campestris pv. campestris, and the results were observed until 72 h, as shown in Fig. 5. Furthermore, the concentration of all the nanomaterials was reduced to 2 mg ml−1 and expected to provide better results but found no reactivity of nanomaterials against phytopathogen. This suggests that the density of NPs at lower concentrations (2 mg ml−1) is so low that the collective strength of NPs is not enough to be defensive against the pathogens. Thus, the 4 mg ml−1 concentration is found to be the optimized reactive concentration against pathogen Xcc, so the results obtained from this concentration are presented here to be analyzed.
 |
| | Fig. 5 Antibacterial activity of synthesized nanomaterials at a 4 mg ml−1 concentration against phytopathogen X. campestris pv. campestris. | |
The obtained results manifest that the chemical TiO2 (C-TiO2) nanoparticles have shown an inhibition zone (IZ) of 10 mm until 24 h, and beyond that, bacterial growth was observed inside the IZ. Thus, Fig. 5 depicts no activity of C-TiO2 NPs against Xcc, while green synthesized TiO2 depicts a 20 mm clear inhibition zone (IZ) up to 48 h. This suggests that the phytochemicals present in neem extract played a role in the bacterium. However, the G-TiO2 NPs could no longer resist the pathogen attack, and bacterial cells could even cover the inhibition zone after 48 h. Similarly, the nanocrystalline cellulose (NCell) extracted from cotton cloth also showed an 18 mm IZ until 48 h and depicted bacteriostatic activity (NPs still resist bacterial growth with a 1 mm clear IZ) against Xcc after 72 h. However, the nanocomposites (CNC and GNC) showed promising results even after 72 h. The nanocomposite (CNC) of NCell and chemically synthesized TiO2 manifests a 30 mm IZ up to 48 h and even beyond that showed a 24 mm IZ up to 72 h, whereas the nanocomposite (GNC) of NCell and green synthesized TiO2 demonstrated a 44 mm IZ even after 72 h. It significantly involves the action of phytochemicals associated with neem (Azadirachta indica). Firstly, the neem extract acts as a capping agent responsible for particle size reduction. Secondly, the phytochemicals present in neem also played defensive roles against pathogens, either by weakening the bacterial cell wall or slowing cell growth. The reactivity of GNC against Xcc up to 72 h evidences the synergistic effect of NCell and G-TiO2 NPs as well as the strong defensive role of phytochemical-rich neem extract against phytopathogen.
It is necessary to investigate that the nanomaterial showing activity against phytopathogens should not harm plant health. Thus, all the synthesized nanomaterials tested against pathogens Bacillus subtilis (BS) and Pseudomonas fluorescens (PSFL) are biocontrol agents maintaining plant health. The results shown in Fig. 6a manifest the activity of nanomaterials against the biocontrol B. subtilis (BS). Green synthesized TiO2 and its corresponding nanocomposite (GNC) inhibited the bacterial growth until 48 h with an 8 mm and a 20 mm IZ, respectively. In spite of this, the nanomaterials (G-TiO2 and GNC) could no longer resist bacterial growth beyond 48 h and became ineffective against pathogen BS. On the other hand, Fig. 6b also depicts similar results that P. fluorescens growth was inhibited by green synthesized TiO2 (GNC) with a 6 mm IZ until 48 h, but these NPs could not be effective for another 24 h (no IZ after 72 h). This suggests that the nanomaterials which showed activity against phytopathogens Xcc are not harmful against biocontrol agents BS and PSFL. The measurement of the inhibition zone observed from antibacterial testing of all the nanomaterials against phytopathogens is noted in Table 3, which indicates the potential of the prepared nanocomposites.
|
| | Fig. 6 (a) Agar well diffusion assay testing of nanomaterials at a 4 mg ml−1 concentration against biocontrol agent Bacillus subtilis (BS). (b) Agar well diffusion assay testing of nanomaterials at a 4 mg ml−1 concentration against biocontrol agent Pseudomonas fluorescens (PSFL). | |
Table 3 Measurement of the inhibition zone observed from antibacterial testing of nanomaterials against phytopathogens. NI represents no inhibition
| Materials |
Zone of inhibition (mm) |
| Xcc |
BS |
PSFL |
| 48 h |
72 h |
48 h |
72 h |
48 h |
72 h |
| NCell |
18 |
NI |
NI |
NI |
NI |
NI |
| C-TiO2 |
NI |
NI |
NI |
NI |
NI |
NI |
| G-TiO2 |
20 |
NI |
8 |
NI |
NI |
NI |
| CNC |
30 |
24 |
NI |
NI |
NI |
NI |
| GNC |
60 |
44 |
20 |
NI |
6 |
NI |
3.5 The defense mechanism of nanomaterials against pathogens
The obtained antibacterial results were analyzed based on the observed inhibition zone. Fig. 7 attempts to explain the scenario inside the inhibition zone, or the defence mechanism of the material against pathogens, using TEM images of untreated Xcc and treated Xcc by the G-TiO2 nanomaterial as an example. In this respect, a very small area inside the inhibition zone of the G-TiO2 plate (72 h) was swept out, dispersed in autoclaved DI water, and further used to prepare the TEM grid for testing. It is seen from Fig. 7 that the untreated bacterium is a rod-shaped microorganism with a fine thick cell wall and thread-like flagella. On the other hand, there are two types of defensive action during a pathogen treatment with a nanomaterial: bactericidal and bacteriostatic. In this example case, G-TiO2 showed bactericidal action until 48 h showing a clear inhibition zone. This means the nanoparticles could successfully rupture the bacterial cell wall and penetrate the cell to kill it. However, after 48 h, the strength of nanoparticles decreases with further bacterial growth. Although, at this stage (after 48 h), G-TiO2 NPs could not penetrate the bacterial cell, they are still effective enough to weaken or inactivate the bacterium making it unconscious. It basically suppresses the growth of bacterial cells, keeping them in a stationary phase of growth known as a bacteriostatic condition. Thus, the TEM images recorded for the sample inside the inhibition zone of the 72 h condition of the G-TiO2 sample plate show dead cells with ruptured cell walls and deactivated cells, also depicting bacteriostatic conditions.
 |
| | Fig. 7 Schematic of TEM images depicting the action on green synthesized TiO2 on phytopathogen X. campestris pv. campestris (Xcc). | |
3.6 Antifungal studies of synthesized nanomaterials
The antifungal activity of prepared nanocomposites in comparison with their parent components was analyzed using poison food agar assay against pathogens Fusarium graminearum and Phytophthora spp., and the results are presented in Fig. 8. Since the antibacterial studies revealed 4 mg ml−1 to be the optimized concentration, this concentration is considered a reference for antifungal studies. However, it was found that all the nanomaterials at 4, 2, 1, and 0.5 mg ml−1 concentrations exhibited the complete inhibition of mycopathogens Fusarium g. and Phytophthora spp. even after 7 days, and the control plate showed full fungus growth within 5 days. Thus, the nanomaterial concentration was further lowered to find the minimum optimized concentration effective against fungus. Fig. 8a shows the antifungal results of nanomaterials at 0.25 and 0.125 mg ml−1 concentrations against Fusarium graminearum (FG). It has been found that the 0.25 mg ml−1 concentration is strongly effective against FG as all the nanomaterials completely inhibit the fungal growth. However, the results at the 0.125 mg ml−1 concentration are quite different, but the nanomaterials are still effective against FG as they showed restricted growth compared with the control plate. Moreover, the PDA plate consisting of G-TiO2 showed no fungal growth, while only the plug of 3-day mycelial growth placed in the PDA plate of GNC is covered with fungus FG and could not grow beyond due to the defensive action of GNC NPs. Thus, this suggests that the green synthesized TiO2 and its corresponding nanocomposite completely inhibit the fungal growth even at 0.125 mg ml−1 concentration and thus prove their potential for preventing FHB diseases caused by F. graminearum in wheat and barley.
|
| | Fig. 8 (a) Poison food agar assay testing of all the nanomaterials at 0.25 and 0.125 mg ml−1 concentrations against F. graminearum under in vitro conditions. (b) Poison food agar assay testing of all the nanomaterials at a 0.125 mg ml−1 concentration against Phytophthora spp. under in vitro conditions. | |
However, all the nanomaterials exhibited strong inhibition of fungal growth of Phytophthora spp. even at 0.125 mg ml−1 concentration, as shown in Fig. 8b. It can be seen that the control plate showed full fungal growth within 5 days while all the nanomaterials exhibited complete inhibition and thus are strongly effective against Phytophthora spp. This suggests that all the prepared nanomaterials have the ability to control water and soil-borne diseases caused by Phytophthora spp. in citrus.
Thus, the obtained antimicrobial results manifest that the synergistic effects of nanocrystalline cellulose and TiO2 are stronger than those of the individual nanomaterials. Moreover, the Azadirachta indica leaf extract contributed well to the defense mechanism against pathogens. The phytochemicals in green extract acted as a reducing agent during synthesis and as a capping agent to stop further growth and maintain smaller particle sizes. So, the phytochemicals help weaken the bacterial cell wall so that smaller-sized particles61,62 easily penetrate the cytoplasm by damaging the cell wall and rupturing the membrane, causing vacuole formation due to increased NP concentration in the cell, inhibiting cell growth, and finally opening the death pathways for pathogens either by deactivating or killing the bacteria. Hence, the nanocomposite of cotton cloth extracted nanocrystalline cellulose with green synthesized TiO2 has proved its potential to be a good antimicrobial agent for crop protection in agriculture.
4. Conclusions
This work presents two different non-toxic, biocompatible compounds to prepare environmentally friendly nanocomposites. A waste product (waste cotton cloth) has been recycled successfully used to prepare cellulose nanoparticles and tested against pathogens. Another biocompatible compound TiO2 has been green synthesized by using Azadirachta indica leaf extract to utilize the effects of phytochemicals against pathogens. Moreover, commercially available TiO2 has also been used for comparison. So, two nanocomposites of nanocrystalline cellulose (NCell) have been prepared, one with chemical TiO2 and another with green TiO2. All the nanomaterials (NCell, C-TiO2, G-TiO2, CNC and GNC) were analysed by XRD, UV-visible spectroscopy and TEM. The results obtained from XRD and UV-visible spectroscopy evidence the contribution of NCell and TiO2 in nanocomposites. The TEM results demonstrate the particle size of nanomaterials and prove that GNC particle size is smaller than that of CNC. The prepared nanocomposites, in comparison with individual parent components, have been examined against phytopathogens: Xanthomonas campestris pv. campestris and two biocontrol agents – Bacillus subtilis and Pseudomonas fluorescens; fungal pathogens: Fusarium graminearum and Phytophthora spp. It is evident from the antibacterial results against Xcc that only the nanocomposites CNC and GNC showed bactericidal action even after 72 h with an inhibition zone of 24 and 44 mm, respectively. However, comparing CNC and GNC with each other, the phytochemicals present in the green extract are responsible for stronger and longer defensive actions of the GNC nanocomposite against Xcc compared to CNC. Similarly, the nanocomposites have proved their efficiency against fungi F. graminearum and Phytophthora spp. Moreover, all the prepared nanomaterials have not affected the growth of B. subtilis and P. fluorescens, which are biocontrol agents helping to maintain plant health. Thus, the results evidently demonstrated that the nanocomposites exhibited enhanced antimicrobial activity compared to their individual components, with the green-synthesized TiO2 showing superior performance. This enhanced efficacy is attributed to the synergistic effects of TiO2 and cellulose, which disrupt bacterial and fungal cell walls more effectively. The nanocomposites also displayed excellent biocompatibility, ensuring that they do not harm beneficial microbes. The green synthesis method further reduced particle agglomeration, improved stability, and minimized environmental impact, aligning with sustainability principles. This approach highlights the potential of waste-derived nanomaterials in sustainable agriculture. Using cellulose extracted from waste cotton cloth not only reduces waste but also creates value-added products for agricultural applications. Similarly, green synthesis using neem extract leverages natural resources to produce environmentally friendly nanoparticles without hazardous chemicals. Thus, the present study demonstrates that nanocomposites of cellulose and TiO2, particularly those synthesized using green methods, offer a promising solution for managing plant diseases. These materials provide effective antimicrobial action against harmful pathogens while preserving beneficial biocontrol agents. Their cost-effectiveness, environmental safety, and scalability make them suitable for widespread agricultural use. By integrating advanced nanotechnology with sustainable practices, this work contributes to improving crop protection and ensuring global food security.
Data availability statement
The raw/processed data required to reproduce the above findings cannot be shared at this time due to legal/ethical reasons.
Author contributions
Chhavi Sharma: conceptualization, original draft, methodology, investigation, data curation, and experimentation. Archana Rana and Amit Kumar Kesharwani: resources and software. Dinesh Singh: supervision for antimicrobial testing and analysis. Ritu Srivastava: co-supervision & editing. Shailesh Narain Sharma: supervision; validation; visualization; review & editing.
Conflicts of interest
The authors declare that they have no known competing financial interests or personal relationships that could have appeared to influence the work reported in this paper.
Acknowledgements
The authors express gratitude to Director CSIR-NPL for permitting them to utilize facilities to execute the research work. C. Sharma sincerely acknowledges the Academy of Scientific and Innovative Research (AcSIR) to pursue a PhD at CSIR-NPL.
References
- S. Savary, L. Willocquet, S. J. Pethybridge, P. Esker, N. McRoberts and A. Nelson, Nat. Ecol. Evol., 2019, 3, 430–439 CrossRef PubMed.
- X.-F. Xin, B. Kvitko and S. Y. He, Nat. Rev. Microbiol., 2018, 16, 316–328 CrossRef CAS PubMed.
- L. Perincherry, J. Lalak-Kańczugowska and Ł. Stępień, Toxins, 2019, 11, 664 CrossRef CAS PubMed.
- M. J. Hajipour, K. M. Fromm, A. Akbar Ashkarran, D. Jimenez de Aberasturi, I. R. de Larramendi, T. Rojo, V. Serpooshan, W. J. Parak and M. Mahmoudi, Trends Biotechnol., 2012, 30, 499–511 CrossRef CAS PubMed.
- N.-Y. T. Nguyen, N. Grelling, C. L. Wetteland, R. Rosario and H. Liu, Sci. Rep., 2018, 8, 16260 CrossRef PubMed.
- L. Miao, C. Wang, J. Hou, P. Wang, Y. Ao, Y. Li, N. Geng, Y. Yao, B. Lv, Y. Yang, G. You and Y. Xu, Bioresour. Technol., 2016, 216, 537–544 CrossRef CAS PubMed.
-
C. López de Dicastillo, M. Guerrero Correa, F. B. Martínez, C. Streitt and M. José Galotto, in Antimicrobial Resistance – A One Health Perspective, ed. M. Mareş, S. Hua Erin Lim, K.-S. Lai and R.-T. Cristina, IntechOpen, 2021 Search PubMed.
- Y. He, S. Ingudam, S. Reed, A. Gehring, T. P. Strobaugh and P. Irwin, J. Nanobiotechnol., 2016, 14, 54 CrossRef PubMed.
- J. Chen, H. Peng, X. Wang, F. Shao, Z. Yuan and H. Han, Nanoscale, 2014, 6, 1879–1889 RSC.
- S. Shamaila, N. Zafar, S. Riaz, R. Sharif, J. Nazir and S. Naseem, Nanomaterials, 2016, 6, 71 CrossRef PubMed.
- K. Markowska, A. M. Grudniak and K. I. Wolska, Acta Biochim. Pol., 2013, 60, 523–530 Search PubMed.
- J. Chen, L. Wu, M. Lu, S. Lu, Z. Li and W. Ding, Front. Microbiol., 2020, 11, 365 CrossRef PubMed.
- J. Pečenka, Z. Bytešníková, T. Kiss, E. Peňázová, M. Baránek, A. Eichmeier, D. Tekielska, L. Richtera, R. Pokluda and V. Adam, Mater. Today Commun., 2021, 27, 102284 CrossRef.
- B. Thomas, M. C. Raj, A. K. B., R. M. H., J. Joy, A. Moores, G. L. Drisko and C. Sanchez, Chem. Rev., 2018, 118, 11575–11625 CrossRef CAS PubMed.
- K. Heise, E. Kontturi, Y. Allahverdiyeva, T. Tammelin, M. B. Linder, Nonappa and O. Ikkala, Adv. Mater., 2021, 33, 2004349 CrossRef CAS PubMed.
- K. J. Edgar, C. M. Buchanan, J. S. Debenham, P. A. Rundquist, B. D. Seiler, M. C. Shelton and D. Tindall, Prog. Polym. Sci., 2001, 26, 1605–1688 CrossRef CAS.
- M. Rose and R. Palkovits, Macromol. Rapid Commun., 2011, 32, 1299–1311 CrossRef CAS PubMed.
- S. Kalia, A. Dufresne, B. M. Cherian, B. S. Kaith, L. Avérous, J. Njuguna and E. Nassiopoulos, Int. J. Polym. Sci., 2011, 2011, 1–35 Search PubMed.
- I. Siró and D. Plackett, Cellulose, 2010, 17, 459–494 CrossRef.
- S. Ummartyotin and C. Pechyen, Carbohydr. Polym., 2016, 142, 133–140 CrossRef CAS PubMed.
- L. Zheng, S. Li, J. Luo and X. Wang, Front. Bioeng. Biotechnol., 2020, 8, 593768 CrossRef PubMed.
- R. Koshani, J. Zhang, T. G. M. van de Ven, X. Lu and Y. Wang, ACS Sustain. Chem. Eng., 2021, 9, 10513–10523 CrossRef CAS.
- D. Georgouvelas, H. N. Abdelhamid, J. Li, U. Edlund and A. P. Mathew, Carbohydr. Polym., 2021, 264, 118044 CrossRef CAS PubMed.
- V. A. Spirescu, C. Chircov, A. M. Grumezescu, B. Ştefan Vasile and E. Andronescu, Int. J. Mol. Sci., 2021, 22, 4595 CrossRef CAS PubMed.
- V. Rodríguez-González, C. Terashima and A. Fujishima, J. Photochem. Photobiol., C, 2019, 40, 49–67 CrossRef.
- X.-X. Chen, B. Cheng, Y.-X. Yang, A. Cao, J.-H. Liu, L.-J. Du, Y. Liu, Y. Zhao and H. Wang, Small, 2013, 9, 1765–1774 CrossRef CAS PubMed.
- K. P. Priyanka, T. H. Sukirtha, K. M. Balakrishna and T. Varghese, IET Nanobiotechnol., 2016, 10, 81–86 CrossRef PubMed.
- B. Kim, D. Kim, D. Cho and S. Cho, Chemosphere, 2003, 52, 277–281 CrossRef CAS PubMed.
- J.-W. Liou and H.-H. Chang, Arch. Immunol. Ther. Exp., 2012, 60, 267–275 CrossRef CAS PubMed.
- H. A. Foster, I. B. Ditta, S. Varghese and A. Steele, Appl. Microbiol. Biotechnol., 2011, 90, 1847–1868 CrossRef CAS PubMed.
- M. R. Khan and Z. A. Siddiqui, Gesunde Pflanz., 2021, 73, 445–464 CrossRef CAS.
- Q. Zhang, X. Yan, R. Shao, H. Dai and S. Li, J. Wuhan Univ. Technol., Mater. Sci. Ed., 2014, 29, 407–409 CrossRef CAS.
- M. A. Irshad, R. Nawaz, M. Zia ur Rehman, M. Imran, J. Ahmad, S. Ahmad, A. Inam, A. Razzaq, M. Rizwan and S. Ali, Chemosphere, 2020, 258, 127352 CrossRef CAS PubMed.
- B. K. Thakur, A. Kumar and D. Kumar, S. Afr. J. Bot., 2019, 124, 223–227 CrossRef CAS.
- A. K. Kesharwani, D. Singh, A. Kulshreshtha, A. S. Kashyap, A. S. Avasthi and N. Geat, Plant Dis., 2023, 107, 212 CrossRef PubMed.
- D. Singh, P. S. Rathaur and J. G. Vicente, Plant Pathol., 2016, 65, 1411–1418 CrossRef CAS.
- D. Singh, A. K. Kesharwani, K. Singh, S. Jaiswal, M. A. Iquebal, N. Geat and A. S. Avasthi, Plant Dis., 2022, 106, 1502–1505 CrossRef PubMed.
- S. Sreelatha, N. Kumar and S. Rajani, Front. Microbiol., 2022, 13, 1085113 CrossRef PubMed.
- A. Varympopi, A. Dimopoulou, I. Theologidis, T. Karamanidou, A. Kaldeli Kerou, A. Vlachou, D. Karfaridis, D. Papafotis, D. G. Hatzinikolaou, A. Tsouknidas and N. Skandalis, Pathogens, 2020, 9, 1024 CrossRef CAS PubMed.
- H. Peng and I. A. Chen, ACS Nano, 2019, 13(2), 1244–1252 CAS.
- S. Malmir, A. Karbalaei, M. Pourmadadi, J. Hamedi, F. Yazdian and M. Navaee, Carbohydr. Polym., 2020, 234, 115835 CrossRef CAS PubMed.
- M. K. Khan, A. Pandey, T. Athar, S. Choudhary, R. Deval, S. Gezgin, M. Hamurcu, A. Topal, E. Atmaca, P. A. Santos, M. R. Omay, H. Suslu, K. Gulcan, M. Inanc, M. S. Akkaya, A. Kahraman and G. Thomas, 3 Biotech, 2020, 10, 172 CrossRef PubMed.
- M. McMullen, G. Bergstrom, E. De Wolf, R. Dill-Macky, D. Hershman, G. Shaner and D. Van Sanford, Plant Dis., 2012, 96, 1712–1728 CrossRef PubMed.
- J. Graham and E. Feichtenberger, J. Citrus Pathol., 2015, 2(1) DOI:10.5070/C421027203.
-
S. O. Cacciola and G. M. D. S. Lio, in Integrated Management of Diseases Caused by Fungi, Phytoplasma and Bacteria, ed. A. Ciancio and K. G. Mukerji, Springer Netherlands, Dordrecht, 2008, pp. 61–84 Search PubMed.
- D. Singh, D. K. Yadav, S. Sinha, K. K. Mondal, G. Singh, R. R. Pandey and R. Singh, Afr. J. Microbiol. Res., 2013, 7, 5459–5470 CrossRef CAS.
- T. Stein, Mol. Microbiol., 2005, 56, 845–857 CrossRef CAS PubMed.
- G. Ganeshan and A. Manoj Kumar, J. Plant Interact., 2005, 1, 123–134 CrossRef CAS.
- C. Sharma, S. N. Sharma and R. Srivastava, Colloid Polym. Sci., 2022, 300, 1027–1036 CrossRef CAS.
- A. H. Bashal, K. D. Khalil, A. M. Abu-Dief and M. A. El-Atawy, Int. J. Biol. Macromol., 2023, 253, 126856 CrossRef CAS PubMed.
- A. M. Abu-Dief, F. M. M. Alrashedee, K. M. Emran and H. A. Al-Abdulkarim, Inorg. Chem. Commun., 2022, 138, 109251 CrossRef CAS.
- Ž. Antić, R. M. Krsmanović, M. G. Nikolić, M. Marinović-Cincović, M. Mitrić, S. Polizzi and M. D. Dramićanin, Mater. Chem. Phys., 2012, 135, 1064–1069 CrossRef.
- A. D. French, Cellulose, 2014, 21, 885–896 CrossRef CAS.
- D. Bondeson, A. Mathew and K. Oksman, Cellulose, 2006, 13, 171–180 CrossRef CAS.
- J. Gong, J. Li, J. Xu, Z. Xiang and L. Mo, RSC Adv., 2017, 7, 33486–33493 RSC.
- E. M. M. Ibrahim, A. M. Abu-Dief, A. Elshafaie and A. M. Ahmed, Mater. Chem. Phys., 2017, 192, 41–47 CrossRef CAS.
- L. H. Abdel Rahman, A. M. Abu-Dief, R. M. El-Khatib, S. M. Abdel-Fatah, A. M. Adam and E. M. M. Ibrahim, Appl. Organomet. Chem., 2018, 32, e4174 CrossRef.
- T. T. Win, S. Khan and P. Fu, J. Nanotechnol., 2020, 2020, 1–9 CrossRef.
- A. K. Madbouly, M. S. Abdel-Aziz and M. A. Abdel-Wahhab, IET Nanobiotechnol., 2017, 11, 702–708 CrossRef.
- M. AlMatar, E. A. Makky, I. Var and F. Koksal, Curr. Drug Delivery, 2018, 15, 470–484 CrossRef CAS PubMed.
- C. Lee, J. Y. Kim, W. I. Lee, K. L. Nelson, J. Yoon and D. L. Sedlak, Environ. Sci. Technol., 2008, 42, 4927–4933 CrossRef CAS PubMed.
- J. Yu, W. Zhang, Y. Li, G. Wang, L. Yang, J. Jin, Q. Chen and M. Huang, Biomed. Mater., 2014, 10, 015001 CrossRef PubMed.
|
| This journal is © The Royal Society of Chemistry 2025 |
Click here to see how this site uses Cookies. View our privacy policy here.